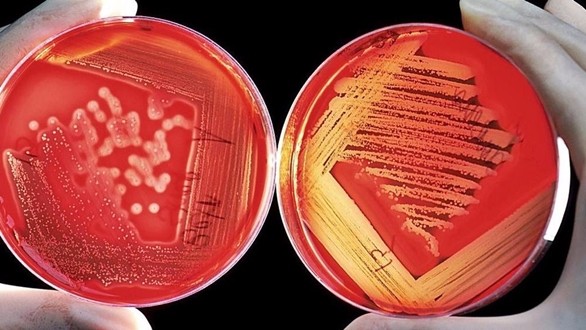
batterio_eschirichia ricerca laboratorio3

Salute, al via il registro nazionale sull’asma grave
L'associazione italiana pneumologi ospedalieri (Aipo), insieme all'associazione allergologi immunologi territoriali ospedalieri (Aaito), lancia il registro nazionale sull'asma grave che, accostandosi...